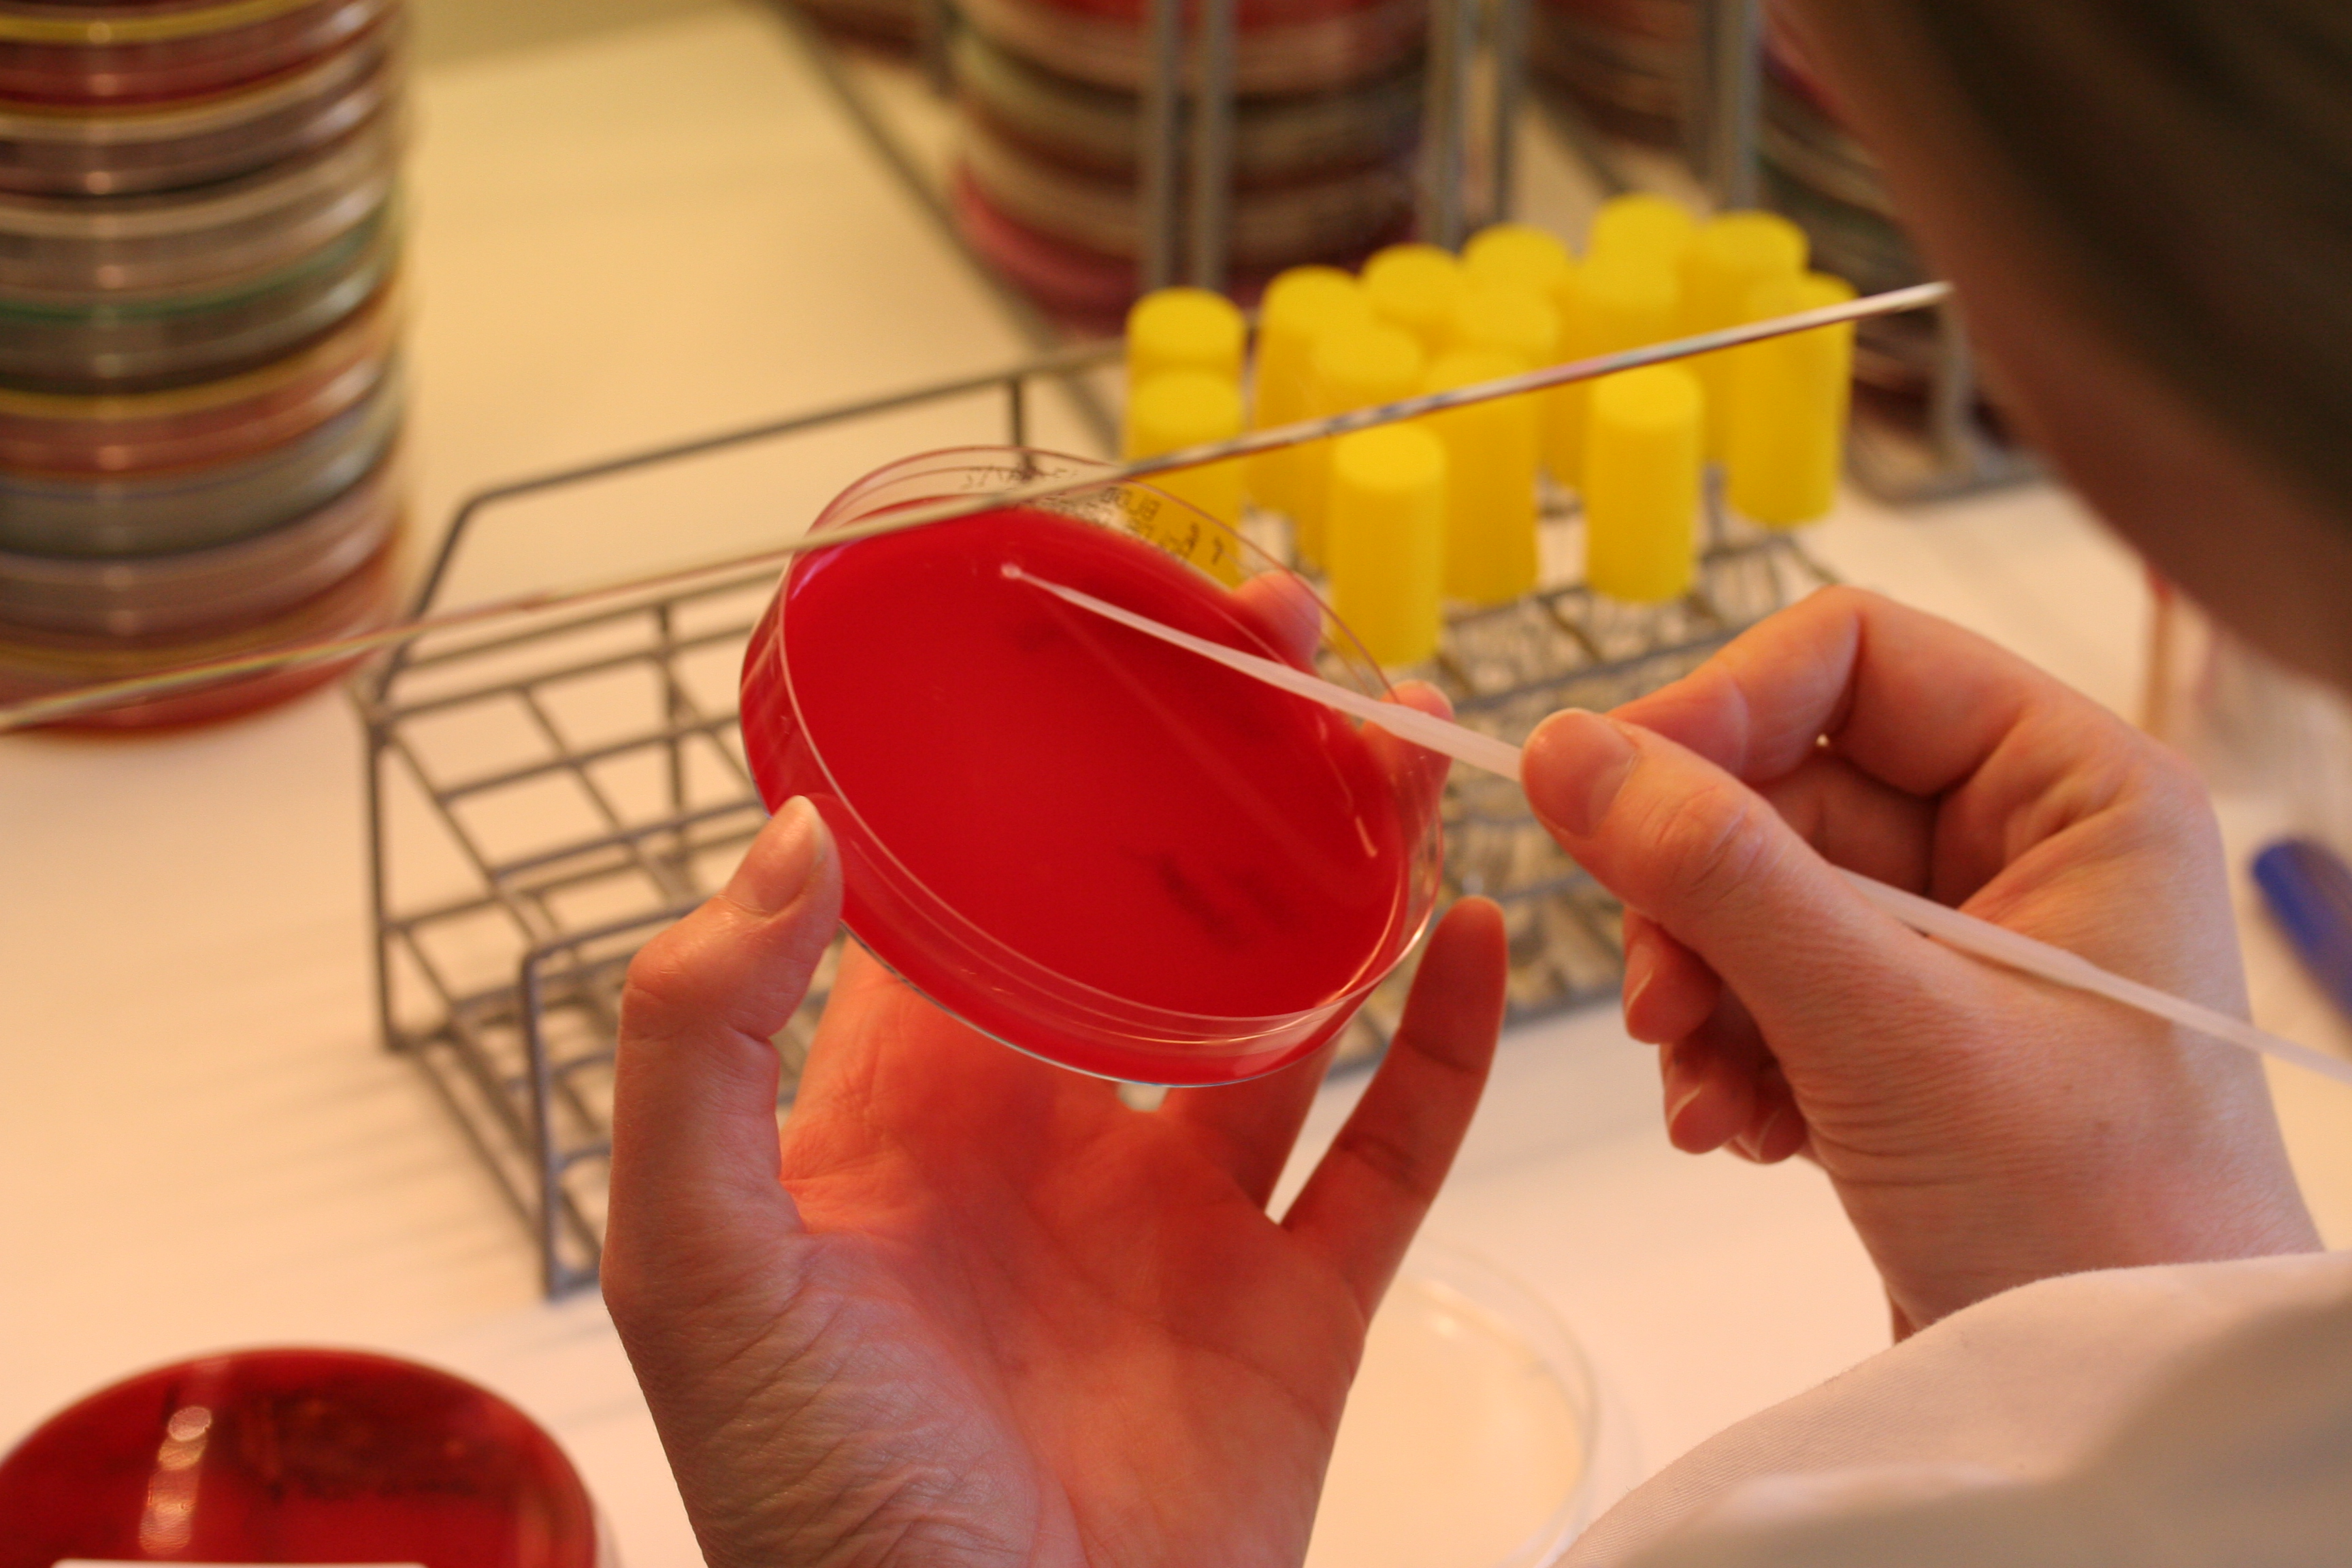
En lab.ansatt som arbeider på mikrobiologisk laboratorium

Ny anbefaling ved påvist karbapenemase
Foto: Helse Bergen
Arbeidsgruppen for antibiotikaspørsmål og metoder for resistensbestemmelse (AFA) varsler endringer i hvordan laboratorier bør rapportere følsomhet for karbapenemer når det er påvist karbapenemase.
Det anbefales nå, på bakgrunn av flere rapporter om behandlingssvikt, at man unngår bruk av karbapenemer (meropenem, imipenem og ertapenem) ved påvist karbapenemase, selv om midlene er testet følsomme.
AFA anbefaler følgende kommentar i laboratoriesvar: "Det er påvist karbapenemase-produksjon. Bruk av karbapenemer (meropenem, imipenem og ertapenem) bør unngås. Konsulter infeksjonsmedisiner eller mikrobiolog."
Ved påvist karbapenemase bør man primært velge andre antibiotika som er testet følsomme. Dersom karbapenemer må brukes, bør høyest mulig dosering benyttes, helst i kombinasjon med et annet aktivt antibiotikum.